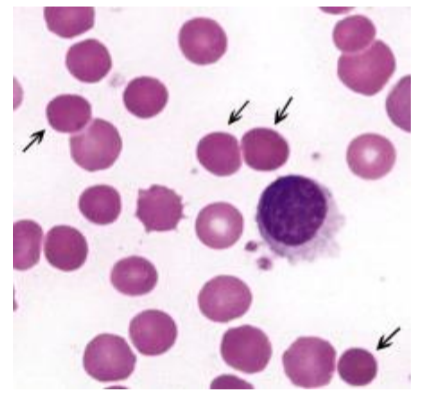

Do redblood cells have a nucleus or organelles?
No
What is the blood composed of?

What is the purpose of erythrocytes being biconcave shaped discs?
Reason: high surface area to volume ratio making it easier to exchange oxygen and carbon dioxide.
Deformability: so the cells can fit into capillaries and swell if needed.
What is the reason for the lack of organelles in RBC’s
To accommodate maximum space for hemoglobin
What is MCHC?
mean cell haemoglobin concentration
(basically the ratio of hemoglobin to the cell volume)
What is the relation between MCHC and the cells viscosity
As MCHC rises viscosity rises
What happens to the properties of erythrocytes as they age
lose membrane surface area, increasing MCHC, making it less deformable.
What are the
Inner:phosphatidylserine and
phosphatidylethanolamine (Es)
Outer: Phosphatidylcholine and sphingomyelin (Cm)
How do Splenic macrophages recognize that a red blood cell is dying?
Phosphatidylserine flips to the outside and the Splenic macrophages bind to it and intiate phagocytosis.
What is the cause of anemia of chronic disease?
During a disease, Inflammation causes C reactive protien to increase which causes more (PS) to flip to the outside causing the destruction of a lot of red blood cells.
What are the proteins involved in the vertical interaction of the red blood cell?
ankyrin, band 3 protein, protein 4.2 and spectrin.
What is hereditary spherocytosis? What causes it?
It is when the red blood cells become more spherical than normal.
Deficiency or abnormalities to the proteins responsible for the vertical interaction of the cell
What are the proteins involved in the horizontal interaction of the red blood cell?
Spectrin and cytoskeletal proteins
What is hereditary elliptocytosis? What causes it?
defects in spectrin and protein 4.1
How do rbc’s produce atp?
anaerobic glycolysis
What is the atp used for in RBCS?
maintain cell volume, shape and flexibility and slow down oxidation (free radicals).
What is osmotic hemolysis.
Atp dependent Na/k pumps, Ca ATPase and aquaporin, maintain osmotic balance in the RBC.
Thus, ATP loss allows Ca and Na influx, and water follows.
This causes the cell to swell and rupture
What is the main cause of defects in glycocitic enzymes?
pyruvate kinase deficiency and it makes up 95% of all defects
What is the second less common cause of defects in glycocitic enzymes?
phosphoglucose isomerase deficiency and it makes up 4%
What is the function of RLP? (Red blood cell, Low oxygen, Ph balance).
It helps red blood cells manage oxygen transport during low oxygen levels or imbalances in the body’s pH. It also allows for the build-up of 2,3DPG, which is important for keeping oxygen levels stable and adjusting how tightly hemoglobin holds onto oxygen.
What are the key metabolic pathways?
RLP
EMP
HMP
What does HMP do?
Makes NADPH which protects RBC from oxidative injury
What is the most common defect in the HMP?
deficiency of glucose-6phosphate dehydrogenase (G6PD).
What are the effects of a G6DP defecincy?
intracellular oxidants are not neutralized and hemoglobin (Hb) gets damaged and clumps together.


